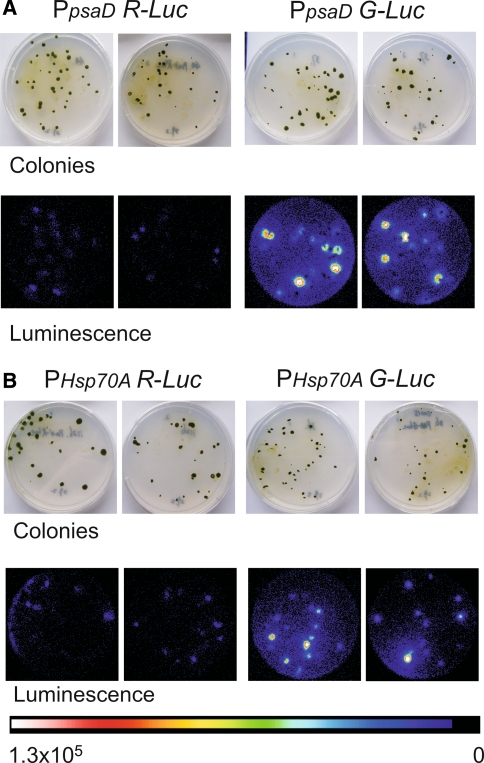
Fig. 5

Abstract
The unicellular green alga Chlamydomonas reinhardtii has emerged as a superb model species in plant biology. Although the alga is easily transformable, the low efficiency of transgene expression from the Chlamydomonas nuclear genome has severely hampered functional genomics research. For example, poor transgene expression is held responsible for the lack of sensitive reporter genes to monitor gene expression in vivo, analyze subcellular protein localization or study protein–protein interactions. Here, we have tested the luciferase from the marine copepod Gaussia princeps (G-Luc) for its suitability as a sensitive bioluminescent reporter of gene expression in Chlamydomonas. We show that a Gaussia luciferase gene variant, engineered to match the codon usage in the Chlamydomonas nuclear genome, serves as a highly sensitive reporter of gene expression from both constitutive and inducible algal promoters. Its bioluminescence signal intensity greatly surpasses previously developed reporters for Chlamydomonas nuclear gene expression and reaches values high enough for utilizing the reporter as a tool to monitor responses to environmental stresses in vivo and to conduct high-throughput screenings for signaling mutants in Chlamydomonas.
Keywords: Reporter gene, Chlamydomonas reinhardtii, Luciferase, Gaussia princeps, Heat-inducible expression, Bioluminescence
Introduction
The unicellular green alga Chlamydomonas reinhardtii has become an invaluable model organism for plant biology (Harris 2001; Gutman and Niyogi 2004; Pröschold et al. 2005). It represents one of the simplest photosynthetic eukaryotes, can be easily grown at large scale either photoautotrophically, mixotrophically or heterotrophically, and can be propagated sexually or asexually. Moreover, Chlamydomonas combines a powerful genetics with the availability of unique genetic and genomic resources: all three genomes are fully sequenced (nuclear, plastid, and mitochondrial; Merchant et al. 2007), large mutant collections have been established, and all three genomes are amenable to genetic manipulation by transformation (Hippler et al. 1998; Remacle et al. 2006). One of the few drawbacks of Chlamydomonas is that it has been notoriously difficult to express transgenes to reasonably high levels from the nuclear genome. Use of specialized promoters (Schroda et al. 2000; Fischer and Rochaix 2001) and adjustment of the transgene’s codon usage to that of the highly GC-rich nuclear genome of the alga (Fuhrmann et al. 1999, 2004) helped in some cases, but no general solution to the problem has been found to date. This is highly unfortunate, because a number of valuable tools available in higher plants currently cannot be used routinely in Chlamydomonas. These include all applications of in vivo reporters of gene expression, such as, promoter-YFP/GFP fusions for gene expression analyses and subcellular localization studies, as well as fluorescence resonance energy transfer (FRET) and biomolecular fluorescence complementation (BiFC) for monitoring protein–protein interactions.
Recently, codon-optimized reporter genes have been developed for nuclear and chloroplast expression in C. reinhardtii. Two such genes have been developed for nuclear expression: a gfp gene encoding the green fluorescent protein from the jellyfish Aequorea victoria (Fuhrmann et al. 1999) and a luciferase gene (R-Luc) from the sea pansy Renilla reniformis (Fuhrmann et al. 2004). Synthetic luciferase and gfp genes were also designed for chloroplast transformation and successfully used to measure plastid gene expression (Minko et al. 1999; Mayfield and Schultz 2004; Barnes et al. 2005). However, the use of these reporter genes for nuclear transformation is still far from being routine. While both reporters allowed detection or quantitation of the expression of some (fusion) genes (Fuhrmann et al. 1999; Shao et al. 2007), their generally low sensitivity has precluded the universal use of these reporters.
To overcome these limitations, we have explored a recently discovered new luciferase for its suitability as a more sensitive reporter of gene expression in Chlamydomonas. The luciferase from the copepod marine organism Gaussia princeps represents one of the smallest and brightest bioluminescent proteins known to date (Tannous et al. 2005; Remy and Michnick 2006). In an ATP-independent reaction, it catalyzes the oxidation of the substrate coelenterazine resulting in light emission at a wavelength of 480 nm. The Gaussia luciferase gene (G-Luc) has been successfully used as a reporter of gene expression in mammalian cells (Tannous et al. 2005) and could also be split and used for the detection of protein–protein interactions by protein fragment complementation assays (Remy and Michnick 2006). It encodes a non-toxic, monomeric protein of only 185 amino acids and this small size may make it particularly suitable for expression in recalcitrant species.
We report here the development of the luciferase gene from G. princeps as a sensitive reporter gene for the in vivo monitoring of gene expression in Chlamydomonas. A codon-optimized version of the gene fused to Chlamydomonas expression signals generated more than 7-fold higher bioluminescence activity than the R-Luc gene from R. reniformis. Furthermore, G-Luc displayed drastically higher signal intensity than R-Luc in luminescence imaging (about 40-fold), thus facilitating the in vivo monitoring of responses to environmental stress stimuli in C. reinhardtii.
Materials and methods
Algal strains and culture conditions
Chlamydomonas reinhardtii strain 325 (CW15,mt+, arg7–8) was used in this study (kindly provided by Dr. Christoph F. Beck, University of Freiburg, Germany). Cultures were grown mixotrophically in Tris–acetate phosphate (TAP) medium (Harris 1989) on a rotary shaker at 23°C under continuous irradiation with white light (55 μE m−2 s−1). The TAP medium was supplemented with 100 mg l−1 of arginine when required.
Nucleic acid manipulations
The coding region of the G. princeps luciferase gene (G-Luc) was synthesized de novo according to the nuclear codon usage of C. reinhardtii (GenScript, Piscataway, NJ). The synthetic G-Luc gene (GenBank accession number EU372000) was ligated as NdeI/EcoRI fragment into the similarly digested PsaD expression cassette (Fischer and Rochaix 2001). Analogously, a codon-optimized R. reniformis luciferase gene (R-Luc; Fuhrmann et al. 2004) was cloned as NdeI/EcoRI fragment into the PsaD cassette. For inducible expression, the G-Luc coding region was excised by digestion with HincII and BamHI and inserted into an inducible expression cassette driven by the Hsp70A promoter (Shao et al. 2007; Fig. 1b).
Fig. 1.
Codon usage optimization of the G. princes luciferase and construction of expression cassettes for the transformation of Chlamydomonas reinhardtii. a Adaptation of the G-Luc gene to the codon usage in the nuclear genome of Chlamydomonas reinhardtii. The relative frequencies of the individual codons of the native G-Luc gene (GenBank accession number AY015993) in the Chlamydomonas nuclear genome are indicated by grey bars with the most frequently used triplet in Chlamydomonas set to 100%. The synthetic G-Luc gene (diamonds) was optimized by changing all codons to the most frequently used ones in Chlamydomonas reinhardtii. bG-Luc and R-Luc expression cassettes. To comparatively assess constitutive expression levels, the G-Luc (dark grey box) and R-Luc (hatched box) coding regions were inserted into the PsaD expression cassette (PsaD promoter and 5′ UTR shown as open box; Fischer and Rochaix 2001). Both the R-Luc (Fuhrmann et al. 2004) and the G-Luc genes are optimized with regard to the codon usage in the Chlamydomonas nuclear genome. For inducible expression, the Hsp70A promoter (from position −23 to −285 with respect to the translation initiation codon of Hsp70A) was fused to a gene fragment containing the 5′ UTR and the first three exons of the Hsp70B gene (Shao et al. 2007). The positions of the three heat shock elements (HSE, black boxes) within the promoter region are indicated. Light grey bars represent exons, introns are depicted as broken lines. The third exon of Hsp70B was fused to the coding region of R-Luc and G-Luc, respectively. The 3′ UTR of the reporter gene cassettes is derived from RBCS2, a nuclear gene for the small subunit of Rubisco (Shao et al. 2007)
Nuclear transformation of Chlamydomonas
Chlamydomonas nuclear co-transformation was carried out using the glass bead method (Kindle 1990). Plasmid DNA used for transformation was purified by PEG precipitation. Prior to transformation, plasmid pCB412 containing the C. reinhardtiiARG7 gene as selectable marker was linearized by digestion with EcoRI; all Luc constructs were linearized with ScaI. Co-transformation and selection for arginine prototrophy were employed to introduce the Luc constructs into the Chlamydomonas nuclear genome. Arginine prototrophic clones were selected on TAP medium. Transformants harboring the Luc constructs were identified by luciferase assays.
Bioluminescence assays
Coelenterazine (P.J.K. GmbH; Kleinblittersdorf, Germany), the substrate for G-Luc and R-Luc, was dissolved in ethanol (1 mM stock solution). To assay luciferase activity, C. reinhardtii cultures were grown in liquid TAP medium under constant illumination (55 μE m−2 s−1) to a final cell density of 3–6 × 106 cells ml−1. After sampling, cells were spun down, resuspended in the same volume of sample buffer [1.5 mM Tris–HCl (pH 7.8), 1 mM EDTA], and frozen at −20°C for at least 20 min. After thawing, 20 μl samples were transferred to 96-well, white microtiter plates and 125 μl of the assay buffer [0.1 M K2HPO4 (pH 7.6), 0.5 M NaCl, 1 mM EDTA] was added to each well. Following incubation at room temperature for 15 min in the dark, bioluminescence was assayed using a luminometer (MicroBeta TriLux; PerkinElmer) by auto-injecting the substrate (coelenterazine 0.01 mM; 50 μl per well). The luminescence units are presented as luminescence counts per second (LCPS). The background was normalized by measuring wells containing only buffer or buffer with cells lacking the Luc gene. Inducible expression of the Luc fusion genes was normalized to the chlorophyll content of the cultures (Porra et al. 1989). The induction factor was calculated by comparison with untreated cells.
For in vivo luminescence imaging, C. reinhardtii cultures were grown in TAP medium under constant illumination (55 μE m−2 s−1) to a final density of 1–2 × 106 cells ml−1. A volume of 3 μl cell suspension were spotted onto TAP agar plates and incubated under constant illumination (55 μE m−2 s−1) for 4 days. Luminescence of the cells was visualized in the presence of the substrate (coelenterazine 0.05 mM) using an ultra sensitive Photon Counting Camera (C2400-30H; Hamamatsu). Samples imaged in the absence of the substrate served as control. The luminescence images were acquired and processed with the HPD-LIS software (Hamamatsu) using an integration time of 20 min and linear signal intensity.
RNA gel blot analyses
Total cellular RNA was extracted according to published protocols (von Gromoff et al. 1989). RNA samples (15 μg total RNA) were electrophoresed in formaldehyde-containing 1% agarose gels and blotted onto Hybond XL membranes (GE Healthcare). To produce a hybridization probe for detection of G-Luc transcripts, the coding region of the gene was excised from a plasmid clone. A Hsp70A-specific probe was prepared from a plasmid clone originally described as hsp70-2 (von Gromoff et al. 1989). The probes were purified by agarose gel electrophoresis following extraction of the DNA fragments of interest from excised gel slices using the Nucleospin Extract II kit (Macherey-Nagel, Düren, Germany) and then radiolabeled with 32P-dCTP using the MegaPrime kit (GE Healthcare). Hybridizations were performed at 65°C in Church buffer (Church and Gilbert 1984).
Results
Design of the Gaussia luciferase as reporter gene for Chlamydomonas
Bioluminescent proteins are widely used as reporter genes to measure gene expression, determine subcellular protein localization, and study protein–protein interactions. Luciferases are nontoxic, bioluminescent reporter proteins suitable to monitor gene expression quantitatively. Unfortunately, the previously constructed Chlamydomonas-specific Renilla luciferase (Fuhrmann et al. 2004) suffers from low sensitivity, presumably due to low expression levels and/or low protein stability. As in mammalian cells, the luciferase from the marine copepod G. princeps proved to be a much more sensitive reporter than firefly and Renilla luciferases (Tannous et al. 2005); we set out to test this luciferase as a reporter gene in C. reinhardtii.
Previous work had shown that, in Chlamydomonas, adaptation of the codon usage of trangenes significantly improves expression levels (Fuhrmann et al. 1999, 2004). As the codon usage in the native luciferase from G. princeps deviated strongly from that in nuclear genes of C. reinhardtii, we adjusted all codons to the most preferred triplets in Chlamydomonas (according to the codon usage table for Chlamydomonas: http://www.kazusa.org.jp/codon; Fig. 1a). Following this codon optimization in silico, the gene was resynthesized and will be subsequently referred to as G-Luc standing for Gaussia luciferase gene (GenBank accession number EU372000). In all subsequent experiments, G-Luc was compared side-by-side to the Renilla luciferases (Fuhrmann et al. 2004), referred to as R-Luc.
Both luciferase genes were cloned into two different expression cassettes: (1) the PsaD cassette (Fischer and Rochaix 2001), whose promoter is constitutively active at least under photosynthetic conditions and (2) an inducible expression cassette driven by the Hsp70A promoter fused to the 5′ region of the Hsp70B gene (Shao et al. 2007; Fig. 1b). This heat shock gene promoter was shown previously to positively respond to a variety of inducing signals, including heat stress, light, retrograde signals from the plastid, and reactive oxygen species (von Gromoff et al. 1989; Kropat et al. 1997; Kropat and Beck 1998; Schroda et al. 2000; Shao et al. 2007). All gene constructs were introduced into arginine-auxotroph Chlamydomonas cells by glass bead-mediated co-transformation followed by selection for arginine prototrophy.
Expression and heat inducibility of the Gaussia luciferase reporter
To compare the sensitivity of the Chlamydomonas-specific G-Luc as a reporter gene with that of the previously designed R-Luc, 24 transgenic clones from each construct with the constitutive PsaD promoter were randomly chosen and the six best-expressing ones were assayed for their luciferase activities. While only three out of six best R-Luc clones had significant luciferase activity, all six G-Luc clones showed high activity (Fig. 2a). Moreover, when the activities were compared quantitatively, the G-Luc clones displayed, on average, more than 7-fold higher bioluminescence signal intensity than the R-Luc clones (Fig. 2a), indicating that the new G-Luc is more sensitive and more efficient than previously established reporter genes for Chlamydomonas. The very high luciferase activities measured indicate that G-Luc will also be suitable for reporting expression from promoters that are considerably weaker than the PsaD promoter.
Fig. 2.
Comparison of G-Luc and R-Luc activity in transgenic Chlamydomonas reinhardtii strains. a Expression of G-Luc and R-Luc under the control of the constitutive PsaD promoter. For each construct, bioluminescence assays with six independent transformants were performed using a luminescence counter. The bars represent the mean of three independent experiments. The standard deviation is indicated. b Heat induction of the G-Luc and R-Luc reporters under the control of the Hsp70A promoter. Expression of luciferase in transformants harboring the PHsp70A-Luc constructs was induced by a temperature shift from 23 to 40°C for 1 h. After a 1 h recovery phase at room temperature, luciferase activity was assayed and the induction factors were calculated by comparison with untreated samples. Four arbitrarily chosen transformants were assayed for each luciferase construct. The bars represent the mean of three independent experiments, the standard deviation is indicated. The basal expression levels of the transformants under non-inducing conditions were 105, 5, 133 and 2 LCPS μg−1 chlorophyll for the four R-Luc clones and 4, 5, 37 and 18 LCPS μg−1 chlorophyll for the four G-Luc clones
Next we wanted to compare the two luciferase genes when expressed under the control of the inducible Hsp70A promoter. To this end, inducibility was determined by measuring luciferase activities in the uninduced and induced states for the four best-expressing co-transformants from each construct (identified among 32 randomly picked clones). Transgene expression was induced by shifting the growth temperature of the algal culture from 23 to 40°C for 1 h. While background expression under non-inducing conditions was comparably low in R-Luc and G-Luc transformants, the G-Luc transformants showed much higher bioluminescence under inducing conditions (on average more than 7-fold; Fig. 2b). This confirms the higher sensitivity of the G-Luc reporter for another expression cassette (Hsp70A promoter + RbcS terminator) and, moreover, indicates that G-Luc can be used as a highly sensitive reporter gene for measuring inducible gene expression in C. reinhardtii.
Luciferase imaging and assessment of protein stability
One of the most powerful applications of luminescent reporter proteins is their use in genetic screens for mutants in cellular signal transduction pathways. This usually requires detection of the reporter gene activity by imaging techniques to facilitate high-throughput screening of mutagenized organisms. Unfortunately, due to the lack of sufficiently sensitive reporters, this has not been possible in Chlamydomonas to date. We, therefore, were interested in testing whether the sensitivity of our new G-Luc reporter gene was sufficiently high to allow visualization of gene expression by luciferase imaging.
To this end, we assayed luciferase activity from both the constitutive and the inducible expression constructs in vivo using a photon-counting camera. Even the best-expressing clone with R-Luc controlled by the PsaD expression cassette (Fig. 2a) did not show enough luminescence to be detectable by luciferase imaging (Fig. 3a). In contrast, G-Luc activity was sufficiently strong to be readily detectable (Fig. 3a). Similar results were obtained for inducible expression from the Hsp70A promoter. While R-Luc activity was barely above the detection limit, inducibility of G-Luc expression was detected with high sensitivity (Fig. 3b).
Fig. 3.
In vivo assay of Gaussia luciferase and Renilla luciferase activities in Chlamydomonas reinhardtii by visualizing luminescence with a photon-counting camera. Left panels show photographs of the algal colonies prior to luminescence imaging, right panels show the luminescence images. The clones with the highest luciferase expression levels in Fig. 2 were used. a For detection of luciferase activity in living algae, wild-type cells (WT) and transformants harboring the PpsaD R-Luc or PpsaD G-Luc constructs (strains R1 and G9 from Fig. 2a) were spotted in three replicas onto agar-solidified medium and grown under normal light conditions (55 μE m−2 s−1) for 4 days. The ratio of luciferase signal intensities of PpsaD G-Luc:PpsaD R-Luc was approximately 40 (40.4 ± 2.5); the signal intensity of PpsaD R-Luc was only slightly above background (PpsaD R-Luc: WT = 3.4 ± 1.5). b Luminescence of the PHsp70A-Luc transformants induced by heat shock. The cultures were shifted from 23 to 40°C for 1 h. After recovery at room temperature for 1 h, the luminescence image was taken with a photon-counting camera. Luminescence intensities are color-coded with the maximum set to 1.3 × 105
Different possible explanations can account for the much better performance of G-Luc compared to R-Luc: higher expression rates, higher enzymatic activity or higher stability of the Gaussia enzyme. To distinguish between these possibilities, we performed stability assays by measuring luciferase activities in dependence on the temperature. To this end, algal cultures were subjected to 30 min of high temperature incubation followed by a 30 min recovery phase at room temperature prior to measurement of luciferase activity. If the Gaussia enzyme were indeed more stable than the Renilla enzyme, its activity should decline less sharply with temperature. This was indeed the case (Fig. 4a): while the Renilla luciferase suffered a strong temperature-dependent decline in activity, the Gaussia enzyme was much less affected, suggesting that higher enzyme stability contributes substantially to the superior performance of G-Luc.
Fig. 4.
Monitoring the heat stress response in Chlamydomonas strains expressing luciferase constructs driven by the heat-inducible Hsp70A promoter. a Assessment of the thermostability of the Gaussia and Renilla luciferases. PpsaD-Luc transformants were subjected to 30 min of high temperature treatment as indicated followed by a 30 min recovery phase at room temperature. Luciferase activities were measured with a luminescence counter. Note the high temperature sensitivity of the Renilla enzyme with all activity being lost at temperatures above 46°C. In contrast, the Gaussia enzyme appears to be much more stable, facilitating its use as a sensitive reporter of heat stress-induced gene expression. b Visualization of the heat stress response with G-Luc. For luciferase imaging, wild-type cells (WT) and transformants harboring PHsp70A R-Luc, PHsp70A G-Luc or P∆HSEG-Luc (G-Luc fusion to a Hsp70A promoter lacking the HSE region; Shao et al. 2007) were spotted in three replicas on agar plates, grown under normal light conditions (55 μE m−2 s−1) for 4 days, photographed (left picture), and then shifted from 23 to 47°C for 15 min. After 3.5 h at room temperature (RT), the luminescence of the transformants upon substrate addition was recorded with a photon-counting camera (right picture). c Analysis of the kinetics of luciferase induction in a PHsp70A G-Luc transformant exposed to heat stress. Colonies of the PHsp70A G-Luc strain growing on a TAP agar plate were exposed to 40 or 47°C for 15 min. After 1, 3 or 5 h recovery at RT, the luminescence of the colonies was visualized using a photon-counting camera. d Comparison of the induction of G-Luc expression by heat stress with induction of the endogenous Hsp70A gene at the mRNA level. Expression from the Hsp70A promoter was induced by a 15-min incubation at 40 or 47°C, and then followed over time by incubation at room temperature (RT) for the time spans indicated. The induction kinetics of luciferase expression from the Hsp70A promoter parallels that of the endogenous Hsp70A gene
To explore the heat inducibility of G-Luc under the control of the Hsp70A promoter in somewhat greater detail, we sought to identify optimum experimental conditions for conducting genetic screens for signaling mutants. We, therefore, tested different combinations of temperatures of the heat shock and recovery times and also included a control construct, in which the heat-shock elements (HSE) were deleted from the Hsp70A promoter (Shao et al. 2007). As expected, this deletion completely abolished heat inducibility under all conditions tested (Fig. 4b and data not shown). Efficient heat induction of the G-Luc reporter was achieved in a wide temperature range, from 40 to 47°C (cp. Figs. 3b, 4b). However, heat shock at higher temperatures required longer recovery times at room temperature before luciferase activity could be visualized by imaging. Whereas following heat shock at 40°C, maximum bioluminescence was measured after 1 h recovery, a recovery phase of 3 h was required to obtain similarly high bioluminescence after a heat shock at 47°C (Fig. 4c).
Next we wanted to confirm that heat induction of luciferase activity parallels G-Luc mRNA accumulation. This was clearly the case upon both induction at 40°C and induction at 47°C (Fig. 4d). At both temperatures, mRNA levels peaked at about the same time as enzyme activities (cp. Fig. 4c, d). Moreover, the kinetics of G-Luc mRNA accumulation correlated, by and large, with heat induction of the endogenous Hsp70A gene (Fig. 4d), ultimately confirming that the luciferase reporter faithfully mirrors promoter activity.
Having established that G-Luc expression can be readily monitored by luminescence imaging, we finally wanted to provide a quantitative assessment of the superior performance of the G-Luc reporter by direct luciferase imaging of primary transformants. To this end, Petri dishes with transformed Chlamydomonas colonies were exposed to the substrate and analyzed by luminescence imaging (Fig. 5). While transformation with G-Luc produced a high number of brightly luminescing colonies, R-Luc luminescence was much lower and barely detectable (Fig. 5). These data ultimately confirm the much higher sensitivity of the G-Luc reporter and its suitability for luminescence imaging.
Fig. 5.
In vivo assay of Gaussia luciferase and Renilla luciferase activities in primary Chlamydomonas transformants by visualizing luminescence with a photon-counting camera. Co-transformation experiments were conducted using identical amounts of linearized DNA (500 ng Luc-containing plasmid + 100 ng ARG7-containing plasmid) and identical amounts of algal cells. Upper panels show photographs of the algal colonies prior to luminescence imaging, lower panels show the luminescence images. Luminescence intensities are color-coded with the maximum set to 1.3 × 105. a Luminescence of PpsaD-Luc transformants. The ratio of total-plate luminescence of PpsaD G-Luc:PpsaD R-Luc was approximately 36. b Luminescence of PHsp70A-Luc transformants induced by heat shock. The cultures were shifted from 23 to 40°C for 1 h. After recovery at room temperature for 1 h, the luminescence image was taken. The ratio of total-plate luminescence of PHsp70A G-Luc:PHsp70A R-Luc was approximately 16. Note that a large fraction of the non-luminescing colonies is not co-transformed (i.e., harbors the selectable marker gene but not the luciferase reporter)
Discussion
In this work, we have established the luciferase from the marine copepod G. princeps as a novel and highly sensitive bioluminescent reporter in the model alga C. reinhardtii. The G-Luc reporter outperforms previously developed reporter genes for Chlamydomonas, improves the monitoring of gene expression and, most importantly, represents the first nuclear reporter gene that is sufficiently sensitive to facilitate in vivo imaging in Chlamydomonas. This expands the toolbox available for Chlamydomonas genetics and cell biology and will make possible experimental approaches that theretofore could not be taken in Chlamydomonas. First and foremost, the possibility to conduct large-scale mutant screens by bioluminescence imaging of live algal colonies will facilitate powerful genetic strategies for the isolation of novel components of all those signal transduction cascades that modify gene expression by targeting specific promoters. For example, the inducible promoter used in this study (Hsp70A) is the target of several distinct signal transduction pathways in response to heat, retrograde signals from the chloroplast, and reactive oxygen species (Shao et al. 2007). Mutagenesis of our algal strains expressing G-Luc from this promoter (Fig. 4b, c), followed by selection for mutants incapable of inducing the luciferase gene in response to a specific stress stimulus, should allow the genetic dissection of the underlying signal transduction pathways. Our preliminary results indicate that reactive oxygen species, which are much weaker inducers of the promoter than heat stress (Shao et al. 2007), induce G-Luc expression sufficiently strongly to facilitate such a screen in a microtiter plate format, although screening on agar plates will require further optimization and improvement of the assay sensitivity.
In mammalian cells, a split version of the Gaussia luciferase was successfully used for the detection of protein–protein interactions in vivo by protein fragment complementation assays (Remy and Michnick 2006). As currently no method is available to identify protein–protein interactions in Chlamydomonas cells, the development of screens for protein interaction partners seems to be a particularly promising future application of the G-Luc reporter.
It should be noted that thus far, the G-luc reporter gene has been tested only in cell wall-deficient Chlamydomonas strains, which are easily transformable. It remains to be tested whether substrate uptake or luminescence imaging are influenced by the more rigid walls present in strains with wild type-like cell wall structure.
Although the Chlamydomonas-specific G-Luc described here provides a workable reporter of gene expression that is significantly more sensitive than previously established reporter genes, our data indicate that the superior performance of the Gaussia luciferase gene is not due to its better expression in C. reinhardtii, but rather due to its very high enzyme stability. Most probably, the adaptation of other widely used reporter genes to C. reinhardtii (like the genes for the fluorescent proteins GFP and YFP) will require a general solution to the transgene expression problem in Chlamydomonas. This could be achieved by either developing novel expression tools or generating dedicated expression strains in which the suspected epigenetic transgene silencing mechanism is inactivated.
Acknowledgments
The authors thank Dr. Christoph Beck (University Freiburg, Germany) for providing algal strains and the cloned HSP70A promoter and Dr. Jean-David Rochaix (University Geneva, Switzerland) for the PsaD expression cassette. Authors are grateful to Dr. Marc Lohse (MPI-MP) for help with codon usage adaptation. This research was supported by grants from the Deutsche Forschungsgemeinschaft (Forschergruppe FOR 504 “Gene Expression and Proteome Dynamics in Chlamydomonas reinhardtii”) and the Bundesministerium für Bildung und Forschung (Systems Biology Initiative FORSYS, project GoFORSYS).
Open Access This article is distributed under the terms of the Creative Commons Attribution Noncommercial License which permits any noncommercial use, distribution, and reproduction in any medium, provided the original author(s) and source are credited.
References
- Barnes D, Franklin S, Schultz J, Henry R, Brown E, Coragliotti A, Mayfield SP (2005) Contribution of 5′- and 3′-untranslated regions of plastid mRNAs to the expression of Chlamydomonas reinhardtii chloroplast genes. Mol Genet Genomics 274:625–636 [DOI] [PubMed]
- Church GM, Gilbert W (1984) Genomic sequencing. Proc Natl Acad Sci USA 81:1991–1995 [DOI] [PMC free article] [PubMed]
- Fischer N, Rochaix J-D (2001) The flanking regions of PsaD drive efficient gene expression in the nucleus of the green alga Chlamydomonas reinhardtii. Mol Genet Genomics 265:888–894 [DOI] [PubMed]
- Fuhrmann M, Oertel W, Hegemann P (1999) A synthetic gene coding for the green fluorescent protein (GFP) is a versatile reporter in Chlamydomonas reinhardtii. Plant J 19:353–361 [DOI] [PubMed]
- Fuhrmann M, Hausherr A, Ferbitz L, Schödl T, Heitzer M, Hegemann P (2004) Monitoring dynamic expression of nuclear genes in Chlamydomonas reinhardtii by using a synthetic luciferase reporter gene. Plant Mol Biol 55:869–881 [DOI] [PubMed]
- Gutman BL, Niyogi KK (2004) Chlamydomonas and Arabidopsis. A dynamic duo. Plant Physiol 135:607–610 [DOI] [PMC free article] [PubMed]
- Harris EH (1989) The Chlamydomonas sourcebook. Academic Press, San Diego
- Harris EH (2001) Chlamydomonas as a model organism. Annu Rev Plant Physiol Plant Mol Biol 52:363–406 [DOI] [PubMed]
- Hippler M, Redding K, Rochaix J-D (1998) Chlamydomonas genetics, a tool for the study of bioenergetic pathways. Biochim Biophys Acta 1367:1–62 [DOI] [PubMed]
- Kindle KL (1990) High-frequency nuclear transformation of Chlamydomonas reinhardtii. Proc Natl Acad Sci USA 87:1228–1232 [DOI] [PMC free article] [PubMed]
- Kropat J, Beck CF (1998) Characterization of photoreceptor and signaling pathway for light induction of the Chlamydomonas heat-shock gene HSP70A. Photochem Photobiol 68:414–419
- Kropat J, Oster U, Rüdiger W, Beck CF (1997) Chlorophyll precursors are signals of chloroplast origin involved in light induction of nuclear heat-shock genes. Proc Natl Acad Sci USA 94:14168–14172 [DOI] [PMC free article] [PubMed]
- Mayfield SP, Schultz J (2004) Development of a luciferase reporter gene, luxCt, for Chlamydomonas reinhardtii chloroplast. Plant J 37:449–458 [DOI] [PubMed]
- Merchant SS, Prochnik SE, Vallon O, Harris EH, Karpowicz SJ, Witman GB, Terry A, Salamov A, Fritz-Laylin LK, Maréchal-Drouard L, Marshall WF, Qu L-H, Nelson DR, Sanderfoot AA, Spalding MH, Kapitonov VV, Ren Q, Ferris P, Lindquist E, Shapiro H, Lucas SM, Grimwood J, Schmutz J, Chlamydomonas Annotation Team, JGI Annotation Team, Grigoriev IV, Rokhsar DS, Grossman AR (2007) The Chlamydomonas genome reveals the evolution of key animal and plant functions. Science 318:245–251 [DOI] [PMC free article] [PubMed]
- Minko I, Holloway SP, Nikaido S, Carter M, Odom OW, Johnson CH, Herrin DL (1999) Renilla luciferase as a vital reporter for chloroplast gene expression in Chlamydomonas. Mol Gen Genet 262:421–425 [DOI] [PubMed]
- Porra RJ, Thompson WA, Kriedemann PE (1989) Determination of accurate extinction coefficients and simultaneous equations for assaying chlorophylls a and b extracted with four different solvents: verification of the concentration of chlorophyll standards by atomic absorption spectroscopy. Biochim Biophys Acta 975:384–394 [DOI]
- Pröschold T, Harris EH, Coleman AW (2005) Portrait of a species: Chlamydomonas reinhardtii. Genetics 170:1601–1610 [DOI] [PMC free article] [PubMed]
- Remacle C, Cardol P, Coosemans N, Gaisne M, Bonnefoy N (2006) High-efficiency biolistic transformation of Chlamydomonas mitochondria can be used to insert mutations in complex I genes. Proc Natl Acad Sci USA 103:4771–4776 [DOI] [PMC free article] [PubMed]
- Remy I, Michnick SW (2006) A highly sensitive protein–protein interaction assay based on Gaussia luciferase. Nat Methods 3:977–979 [DOI] [PubMed]
- Schroda M, Blöcker D, Beck CF (2000) The HSP70A promoter as a tool for the improved expression of transgenes in Chlamydomonas. Plant J 21:121–131 [DOI] [PubMed]
- Shao N, Krieger-Liszkay A, Schroda M, Beck CF (2007) A reporter system for the individual detection of hydrogen peroxide and singlet oxygen: its use for the assay of reactive oxygen species produced in vivo. Plant J 50:475–487 [DOI] [PubMed]
- Tannous BA, Kim D-E, Fernandez JL, Weissleder R, Breakefield XO (2005) Codon-optimized Gaussia luciferase cDNA for mammalian gene expression in culture and in vivo. Mol Therapy 11:435–443 [DOI] [PubMed]
- von Gromoff ED, Treier U, Beck CF (1989) Three light-inducible heat shock genes of Chlamydomonas reinhardtii. Mol Cell Biol 9:3911–3918 [DOI] [PMC free article] [PubMed]